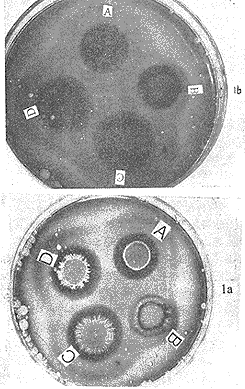

白念珠菌的毒力研究——蛋白酶活力的测定*
作者:温旺荣 王德春 陈 红 朱忠勇
单位:温旺荣 陈红 福建医科大学临床微生物教研室(福州,350004);王德春 朱忠勇 南京军区福州总院全军检验专科中心
关键词:白念珠菌;蛋白酶;毒力
中国人兽共患病杂志990607 摘要 目的 建立一种快速简便测定蛋白酶活力的方法并研究不同来源的临床分离白念珠菌菌株的蛋白酶活力与其毒力的关系。
方法 借助于白念在生物形态分型培养基上以30℃孵育2天后形成特征性红褐色色素环为依据检测蛋白酶活力 。选择3株蛋白酶活力不同的菌株进行小白鼠毒力试验,观察小白鼠死亡率及不同菌株在体内的生长率来探讨蛋白酶与毒力的关系。
结果 从血液、脑脊液和尿液标本分离蛋白酶阳性的菌株检出率与粪便、阴道分泌物、口腔分泌物、皮屑和鼻咽分泌物分离菌株之 间比较有显著性差异(P<0.05),而前者之间的比较无显著性( P>0.05)。动物试验表明蛋白酶活力越强的菌株,小白鼠平均生存时间越短(r=0. 7447,P<0.01),菌株在体内的增殖速度越快,维持时间越长(r=-0.58 80,P<0.05)。
, 百拇医药
结论 不同来源的标本临床分离株蛋白酶活力有明显差别,活力的高低与其毒力有密切相关。该蛋白酶活力测定方法可用于体外直接指示白念毒力。
STUDY ON VIRULENCE-THE ASSAY FOR ACTIVITY OF
PROTEINASE OF CANDIDA ALBICANS
Wen Wangrong1 Wang Dechun2 Chen Hong1 Zhu Zhongyong2
(1.Department of Clinical Microbiology,Fujian Medical University,Fu zhou 350004
2.Center of PLA Medical Laboratory,Fuzhou General Hospital of Nanjing Military Area,Fuzhou 350025)
, 百拇医药
ABSTRACT Aim To establish a rapid simple assay method for a ctivity of proteinase of Candida albicans and study the relatioshi p between the activity and the virulence of proteinase of different C.albi cans isolates from various specimens.
Methods The assay for ac tivity of protein ase of C.albicans based on the characteristic scarlet pigment ring of C.albicans on the bio-morphotyping medium at 30℃ for 2 days.Th e mortality rate of mice injected with three isolates with selected different ac tivities of proteinase and in vivo growth rate of the different isolates were ob served to determine the association between the activity of proteinase and virul ence.
, http://www.100md.com
Results There was significant different positive rate of prote inase between isolates from blood,CSF,urine and feces,vaginal swab,oral cavity,s kin or throat swab(P<0.05).But there was no significant diffe rence among the formers(P>0.05).The animal test showed that the stronger activity of proteinase of C.albicans,the shorter averag esurvival time of mice(r=0.7447,P<0.01),the faster reprodu ctive rate and the longer maintaining time in vivo(r=-0.5880,P<0 .05).
, http://www.100md.com Conclusion Different isolates from various specimens have significantly different activity of proteinase,and the level of activity of pro teinase was deeply associated with their virulence.The assay method for the acti vity of proteinase may directly indicate the virulence of C.albicans in vitro.
KEY WORDS Candida albicans Proteinase Virulence
近年来,白念珠菌(白念)向外分泌的蛋白酶与毒力及致病性关系的报道越来越受到关注[1~4]。国外学者报道白念的致病性与其分泌的蛋白酶密切相关,而且蛋白酶参与白念对表皮侵袭和粘附过程,蛋白酶活力可被其特异的抑制剂抑胃肽完 全抑制[1,2]。有些学者观察到白念粘附力与其蛋白酶分泌量呈平行关系,且有促进粘附力的作用[4]。然而,国内尚无报道。因此,本研究在建立的一种简便快速测定蛋白酶活力方法的基础上,研究不同来源临床分离株的蛋白酶活力以及与其毒力的关系。
, http://www.100md.com
1 材料与方法
1.1 白念蛋白酶活力的测定
1.1.1 标准菌株和临床分离株 标准菌株包括白念珠菌2株(JC1A,JC1B)、类星形念珠菌JC2和高里氏念珠菌1株JC6。均由中国医学科学院皮肤病学研究所真菌室提供;临床分离株由福建医科大学附属第一医院、附属协和医院及南京军区福州总医院全军医学检验中心从临床疑似白念感染病例采集的各种临床标本分离获得,共713株。所有菌株经血清芽管试验、厚膜胞子形成试验及蔗糖同化试验证实为白念,其中来自血液32株,脑脊液5株,尿液24株,痰363株,粪便84株,阴道分泌物48株,口腔分泌物29株,鼻咽分泌物64株和皮屑64株。每一菌株在沙保弱葡萄糖琼脂(SDA)上接种不超过三代,以确保酶活力不改变。
1.1.2 生物形态分型培养基[5] 按配方要求配制,高压灭菌,待温度下降到50℃左右后,每100ml培养基加绵羊血5ml,充分混匀,然后倾注无菌平皿。每一平皿倒入18ml,待凝固后放4℃冰箱保存。一般7天内使用,至多不超过4周。
, 百拇医药
1.1.3 接种 测试菌株在SDA上培养24~48h,以无菌生理盐水制成106~107个菌细胞/ml的菌悬液。用微量加样器滴10μl菌悬液于培养基上,每份标本滴两个点。同时作蛋白酶活力阳性和阴性对照,以避免不同批号试剂对测定结果的影响。平皿在30℃培养48h。
1.1.4 结果测量 在平皿上,能产生蛋白酶的菌株在菌落周围有一明显特征性的红褐色区带色素环如照片所示。蛋白酶活力的值以Pa表示。Pa=菌落直径÷总直径(菌落+色素环)。Pa值越低,表明菌株蛋白酶活力愈强,Pa=1.0即确定为蛋白酶活力阴性。
1.2 白念蛋白酶与毒力的关系
1.2.1 测试菌株 选择3株蛋白酶活力不同的菌株,Ⅰ株Pa=0.34(强蛋白酶活力),Ⅱ株Pa=0.70(弱蛋白酶活力),Ⅲ株Pa=1.00(无蛋白酶活力)。先分别接种于麦芽浸出琼脂[5]30℃孵育48h,用灭菌生理盐水制成菌悬液,再用血球计数器计数孢子数并将其浓度调节至1×107或1×104个菌细胞/ml,采用台盼蓝排除法确定白念活力,要求活力>99%。1×107个菌细胞/ml用于检测小白鼠死亡率,1×104个菌细胞/ml用于检测在其体内生长率。
, 百拇医药
1.2.2 动物 18~22g/只,雄性清洁级KM小白鼠,由中科院上海实验动物中心提供。
1.2.3 毒力测定 用0.1ml接种菌液经尾静脉注射小白鼠,每株同时接种10只小白鼠,每只接种106个菌细胞,每天观察直到30天,记录小白鼠死亡天数及死亡数以计算平均生存时间。每株还同时接种103个菌细胞给另外10只小白鼠,接种后1天及每隔5天杀2只,直到21天,每次取两侧肾脏,称重、匀浆,涂布于麦芽浸出琼脂上,30℃孵育72h作定量培养计数,计算平板菌落数并折算成每克肾脏所含的CFU数目以检测菌株体内生长率。
1.3 统计分析 用卡方检验比较两蛋白酶阳性检出率的差异。
2 结果
2.1 不同来源的白念蛋白酶活力 蛋白酶能分解培养基中的血红蛋白产生明显的色素环。两点标本显示的色素环宽度基本一致。结果见表1。来源于血液的菌株蛋白酶阳性检出率与来源于粪便、阴道分泌物、口腔分泌物、皮屑和鼻咽分泌物菌株相比,经χ2检验,P值均<0.05;但来源于血液、脑脊液、尿液和痰的菌株蛋白酶阳性率相互比较,统计学上无显著性差异(P>0.05)。来源于痰的菌株蛋白酶阳性率与来源于粪便、阴道分泌物、口腔分泌物、皮屑和鼻咽分必物菌株相比,统计学上有显著性差异(P<0.05),来源于痰、口腔分泌物、皮屑菌株蛋白 酶阳性率相互之间统计学上无显著性差异(P>0.05)。
, http://www.100md.com
表1 不同来源的白念菌株蛋白酶活力 菌株来源
菌株数
蛋白酶阳性
菌株数(%)
阳性株色素环
宽度(
±s)
阳性株Pa值
(
±s)
血液
32
, 百拇医药
32(96.9)
9.28±0.16
0.52±0.12
脑脊液
5
5(100)
9.21±0.18
0.50±0.16
尿液
24
24(100)
9.01±0.24
, 百拇医药
0.62±0.10
痰
363
331(91.2)
8.76±0.12
0.72±0.15
粪便
84
69(82.1)
8.74±0.10
0.88±0.07
阴道分泌物
, 百拇医药
48
39(81.3)
8.50±0.13
0.90±0.03
口腔分泌物
29
24(82.8)
8.56±0.16
0.91±0.06
皮屑
64
53(82.8)
, http://www.100md.com
8.64±0.17
0.92±0.05
鼻咽分泌物
64
52(81.3)
8.53±0.20
0.93±0.04
2.2 3株白念以106个菌细胞/只注射小白鼠,Ⅰ株有5只小白鼠在10天内死亡(占50%),其余5只都在25天内死亡,10只小白鼠的平均生存时间为12.2天;Ⅱ株有4只小白鼠在10天内死亡(占40%),其余5只直到30天才死亡,有一只仍存活,9只小白鼠的平均生存时间为14.3天;Ⅲ株注射后25天时,10只小 白鼠仍存活,至30天时才有一只死亡(占10%),平均生存时间为大于30天(图1)。菌株蛋白酶活力(Pa)与小白鼠生存时间存在相关性(r=0.7447,P<0.01 )。表明Ⅰ株毒力强于Ⅱ株,Ⅲ株毒力最弱。
, http://www.100md.com
图1 三株白念(Ⅰ、Ⅱ、Ⅲ)以106个菌细胞注射小白鼠后的死亡率
2.3 3株白念以103个菌细胞/只注射小白鼠后的体内生长率 Ⅰ株白 念在肾脏快速生长,在第10天菌落数达高峰,高达106,至15~20天仍维持在1 05;Ⅱ株白念也是快速生长,但到第10天菌落数达高峰才达105,第20天降到 103;Ⅲ株似乎没有生长且到20天时肾脏未能检出(图2)。经对菌株在体内的生长 率作对数转化后,Pa与其存在负相关(r=-0.5880,P<0.05)。结果显示 Ⅰ株在小白鼠体内生长率最快,维持时间最长;Ⅱ株其次;Ⅲ株基本不生长。
图2 三株白念(Ⅰ、Ⅱ、Ⅲ) 103个菌细胞注射小白鼠后肾脏菌落数
, http://www.100md.com
3 讨论
测定白念蛋白酶活力的方法已有两种,一是由Odds and Abbott报道的借助于BSA琼脂(pH3.8)为基础的检测法[6];二是由Kwon-Chung等建立的以BH琼脂(pH5.5 )为基础的方法[2]。两法是以牛血清白蛋白或牛血红蛋白为基质,观察蛋白酶分解产生的透明圈加以检测的,但孵育时间需要一周,难以适应临床快诊需要。本研究是自制的生物形态分型培养基经接种30℃孵育2天后,白念形成特征性红褐色色素环为依据进行检测的。实验中,在培养基上加入羧基蛋白酶抑制剂抑胃肽(Sigma,2.5μg/ml)时,该色素环完全消失,提示该色素环是白念分泌蛋白酶到培养基,并分解培养基中的血红蛋白所致。抑胃肽对蛋白酶的完全抑制作用与Ray and Payne报道[1]相同。实验还发现类星形念珠菌,个别热带念珠菌和近平滑念珠菌也产生类似色素环,但颜色较淡;而高里氏等其它念珠菌不产生色素环如图所示。该三种念珠菌均可能分泌蛋白酶,但其组成有别于白念的蛋白酶[7]。因此,该法也适用于其它念珠菌的蛋白酶活力的测定,而且该色素环已用于白念的快速分离鉴定[8],还用于白念生物形态分型法[5]的分型依据之一。该法简便,结果易判定,培养基可商品化,且稳定性好,易于推广应用。
, http://www.100md.com
照片 4种标准念珠菌(A、B、C、D)的蛋白酶活力结果(黑白1a,彩色1b)
A,D:白念珠菌JC1A,JC1B;B:高里氏念珠菌JC6;C:类星形 念珠菌JC2
本研究中,自血液和脑脊液的分离株大多数具有致病性,因为蛋白酶阳性率分别达96.9%和100%,Pa值也较低。尿液和痰的菌株大多数也认为有致病性,因蛋白酶阳性率也分别达100%和91.2%,Pa值也不高。为了进一步探讨蛋白酶活力与毒力的关系,本研究选择3株蛋白酶活力不同的菌株进行小白鼠毒力试验。一方面,以106个菌细胞/只注射小白鼠确定死亡率;另一方面,以103个菌细胞/只注射小白鼠以检测白念体内生长率。结果体外产生强蛋白酶活力的Ⅰ株在小白鼠注射25天内就引起致命感染(占100%);弱蛋白酶活力的Ⅱ株在25天内才引起8只小白鼠致命(占80%),到30天才9只死亡(占90%);无蛋白酶活力的Ⅲ株在25天内小白鼠全部存活,到30天才有1只死亡(占10%)。而且Ⅰ株小白鼠平均生存时间短于Ⅱ株,Ⅲ株最长。另外,Ⅰ株在肾脏的生长率快于Ⅱ株,表现在峰值高,上升速度快和下降速度慢。Ⅲ株基本上没有在肾脏生长。小白鼠的死亡率与体内菌株生长率结果基本吻合,提示Ⅰ株毒力强于Ⅱ株,Ⅲ株毒力最弱,说明蛋白酶活力越强,毒力就越强,致病性也越强,即白念毒力强弱与其蛋白酶活力水平密切相关(P<0.05)。Kwon-Chung报道[2]蛋白酶活力是白念的毒力因子之一。Ray and Payne还报道[1]酸性蛋白酶可能参与白念对表皮 角质细胞的粘附与侵袭过程。席丽艳摘报[9]研究证实表皮松解蛋白酶活性与毒力有直接关系。蛋白酶参与白念致病过程的机制值得进一步探讨。
, http://www.100md.com
本研究建立的方法能准确地快速简便检测临床分离白念菌株的蛋白酶活力,且可提供一 种体外直接指示毒力的方法,为进一步研究白念致病性及流行病学调查奠定基础。
*该项目得到福建省教委三项费资助
4 参考文献
1.Ray TL and Payne CD.Scanning Electron Microscopy of Epidermal Adherence and cavitation in Murine Candidiasis:a Role for Candida Acid Protein ase.Infect Immun,1988,56(8):1942.
2.Kwon-Chung KJ,Lehmann D,Good C,et al.Genetic evidence for role of extracellul ar proteinase in virulence of Candida albicans.Infect Immun,1985,49: 571.
, http://www.100md.com
3.Borg M and Ruchel R.Expression of extracellular acid proteinase by proteolytic Candida spp.during experimental infection of the oral mucosa.Infect Immun,1988,56:626.
4.侯幼红.白色念珠菌粘附的研究进展.国外医学微生物学分册,1994,1:23.
5.温旺荣,王德春,戴庚孙,等.白念珠菌的生物形态分型研究.中国人兽共患病杂志,1995, 11(2):11.
6.Odds FC,and Abbott AB.A simple system for the presumptive identification of Candida albicans and differentiation of strains within the species.Sab ouraudia,1980,18:301.
, 百拇医药
7.Ruchel R,Boning B, and Borg M.Characterization of a secretory proteinase of Candida parapsilosis and eidence for the absence of the enzyme during infection in vitro.Infect Immun,1986,53:411.
8.温旺荣,王德春,陈红,等.平板色素环法快速分离鉴定白色念珠菌.福建医科大学学报, 1997,31(1):25.
9.席丽艳摘.白念珠菌表皮松解蛋白酶活力与其对小鼠毒力的关系.国外医学皮肤性病学分册 ,1995,21(2):124.
1998年11月5日收稿, 百拇医药
单位:温旺荣 陈红 福建医科大学临床微生物教研室(福州,350004);王德春 朱忠勇 南京军区福州总院全军检验专科中心
关键词:白念珠菌;蛋白酶;毒力
中国人兽共患病杂志990607 摘要 目的 建立一种快速简便测定蛋白酶活力的方法并研究不同来源的临床分离白念珠菌菌株的蛋白酶活力与其毒力的关系。
方法 借助于白念在生物形态分型培养基上以30℃孵育2天后形成特征性红褐色色素环为依据检测蛋白酶活力 。选择3株蛋白酶活力不同的菌株进行小白鼠毒力试验,观察小白鼠死亡率及不同菌株在体内的生长率来探讨蛋白酶与毒力的关系。
结果 从血液、脑脊液和尿液标本分离蛋白酶阳性的菌株检出率与粪便、阴道分泌物、口腔分泌物、皮屑和鼻咽分泌物分离菌株之 间比较有显著性差异(P<0.05),而前者之间的比较无显著性( P>0.05)。动物试验表明蛋白酶活力越强的菌株,小白鼠平均生存时间越短(r=0. 7447,P<0.01),菌株在体内的增殖速度越快,维持时间越长(r=-0.58 80,P<0.05)。
, 百拇医药
结论 不同来源的标本临床分离株蛋白酶活力有明显差别,活力的高低与其毒力有密切相关。该蛋白酶活力测定方法可用于体外直接指示白念毒力。
STUDY ON VIRULENCE-THE ASSAY FOR ACTIVITY OF
PROTEINASE OF CANDIDA ALBICANS
Wen Wangrong1 Wang Dechun2 Chen Hong1 Zhu Zhongyong2
(1.Department of Clinical Microbiology,Fujian Medical University,Fu zhou 350004
2.Center of PLA Medical Laboratory,Fuzhou General Hospital of Nanjing Military Area,Fuzhou 350025)
, 百拇医药
ABSTRACT Aim To establish a rapid simple assay method for a ctivity of proteinase of Candida albicans and study the relatioshi p between the activity and the virulence of proteinase of different C.albi cans isolates from various specimens.
Methods The assay for ac tivity of protein ase of C.albicans based on the characteristic scarlet pigment ring of C.albicans on the bio-morphotyping medium at 30℃ for 2 days.Th e mortality rate of mice injected with three isolates with selected different ac tivities of proteinase and in vivo growth rate of the different isolates were ob served to determine the association between the activity of proteinase and virul ence.
, http://www.100md.com
Results There was significant different positive rate of prote inase between isolates from blood,CSF,urine and feces,vaginal swab,oral cavity,s kin or throat swab(P<0.05).But there was no significant diffe rence among the formers(P>0.05).The animal test showed that the stronger activity of proteinase of C.albicans,the shorter averag esurvival time of mice(r=0.7447,P<0.01),the faster reprodu ctive rate and the longer maintaining time in vivo(r=-0.5880,P<0 .05).
, http://www.100md.com Conclusion Different isolates from various specimens have significantly different activity of proteinase,and the level of activity of pro teinase was deeply associated with their virulence.The assay method for the acti vity of proteinase may directly indicate the virulence of C.albicans in vitro.
KEY WORDS Candida albicans Proteinase Virulence
近年来,白念珠菌(白念)向外分泌的蛋白酶与毒力及致病性关系的报道越来越受到关注[1~4]。国外学者报道白念的致病性与其分泌的蛋白酶密切相关,而且蛋白酶参与白念对表皮侵袭和粘附过程,蛋白酶活力可被其特异的抑制剂抑胃肽完 全抑制[1,2]。有些学者观察到白念粘附力与其蛋白酶分泌量呈平行关系,且有促进粘附力的作用[4]。然而,国内尚无报道。因此,本研究在建立的一种简便快速测定蛋白酶活力方法的基础上,研究不同来源临床分离株的蛋白酶活力以及与其毒力的关系。
, http://www.100md.com
1 材料与方法
1.1 白念蛋白酶活力的测定
1.1.1 标准菌株和临床分离株 标准菌株包括白念珠菌2株(JC1A,JC1B)、类星形念珠菌JC2和高里氏念珠菌1株JC6。均由中国医学科学院皮肤病学研究所真菌室提供;临床分离株由福建医科大学附属第一医院、附属协和医院及南京军区福州总医院全军医学检验中心从临床疑似白念感染病例采集的各种临床标本分离获得,共713株。所有菌株经血清芽管试验、厚膜胞子形成试验及蔗糖同化试验证实为白念,其中来自血液32株,脑脊液5株,尿液24株,痰363株,粪便84株,阴道分泌物48株,口腔分泌物29株,鼻咽分泌物64株和皮屑64株。每一菌株在沙保弱葡萄糖琼脂(SDA)上接种不超过三代,以确保酶活力不改变。
1.1.2 生物形态分型培养基[5] 按配方要求配制,高压灭菌,待温度下降到50℃左右后,每100ml培养基加绵羊血5ml,充分混匀,然后倾注无菌平皿。每一平皿倒入18ml,待凝固后放4℃冰箱保存。一般7天内使用,至多不超过4周。
, 百拇医药
1.1.3 接种 测试菌株在SDA上培养24~48h,以无菌生理盐水制成106~107个菌细胞/ml的菌悬液。用微量加样器滴10μl菌悬液于培养基上,每份标本滴两个点。同时作蛋白酶活力阳性和阴性对照,以避免不同批号试剂对测定结果的影响。平皿在30℃培养48h。
1.1.4 结果测量 在平皿上,能产生蛋白酶的菌株在菌落周围有一明显特征性的红褐色区带色素环如照片所示。蛋白酶活力的值以Pa表示。Pa=菌落直径÷总直径(菌落+色素环)。Pa值越低,表明菌株蛋白酶活力愈强,Pa=1.0即确定为蛋白酶活力阴性。
1.2 白念蛋白酶与毒力的关系
1.2.1 测试菌株 选择3株蛋白酶活力不同的菌株,Ⅰ株Pa=0.34(强蛋白酶活力),Ⅱ株Pa=0.70(弱蛋白酶活力),Ⅲ株Pa=1.00(无蛋白酶活力)。先分别接种于麦芽浸出琼脂[5]30℃孵育48h,用灭菌生理盐水制成菌悬液,再用血球计数器计数孢子数并将其浓度调节至1×107或1×104个菌细胞/ml,采用台盼蓝排除法确定白念活力,要求活力>99%。1×107个菌细胞/ml用于检测小白鼠死亡率,1×104个菌细胞/ml用于检测在其体内生长率。
, 百拇医药
1.2.2 动物 18~22g/只,雄性清洁级KM小白鼠,由中科院上海实验动物中心提供。
1.2.3 毒力测定 用0.1ml接种菌液经尾静脉注射小白鼠,每株同时接种10只小白鼠,每只接种106个菌细胞,每天观察直到30天,记录小白鼠死亡天数及死亡数以计算平均生存时间。每株还同时接种103个菌细胞给另外10只小白鼠,接种后1天及每隔5天杀2只,直到21天,每次取两侧肾脏,称重、匀浆,涂布于麦芽浸出琼脂上,30℃孵育72h作定量培养计数,计算平板菌落数并折算成每克肾脏所含的CFU数目以检测菌株体内生长率。
1.3 统计分析 用卡方检验比较两蛋白酶阳性检出率的差异。
2 结果
2.1 不同来源的白念蛋白酶活力 蛋白酶能分解培养基中的血红蛋白产生明显的色素环。两点标本显示的色素环宽度基本一致。结果见表1。来源于血液的菌株蛋白酶阳性检出率与来源于粪便、阴道分泌物、口腔分泌物、皮屑和鼻咽分泌物菌株相比,经χ2检验,P值均<0.05;但来源于血液、脑脊液、尿液和痰的菌株蛋白酶阳性率相互比较,统计学上无显著性差异(P>0.05)。来源于痰的菌株蛋白酶阳性率与来源于粪便、阴道分泌物、口腔分泌物、皮屑和鼻咽分必物菌株相比,统计学上有显著性差异(P<0.05),来源于痰、口腔分泌物、皮屑菌株蛋白 酶阳性率相互之间统计学上无显著性差异(P>0.05)。
, http://www.100md.com
表1 不同来源的白念菌株蛋白酶活力 菌株来源
菌株数
蛋白酶阳性
菌株数(%)
阳性株色素环
宽度(
阳性株Pa值
(
血液
32
, 百拇医药
32(96.9)
9.28±0.16
0.52±0.12
脑脊液
5
5(100)
9.21±0.18
0.50±0.16
尿液
24
24(100)
9.01±0.24
, 百拇医药
0.62±0.10
痰
363
331(91.2)
8.76±0.12
0.72±0.15
粪便
84
69(82.1)
8.74±0.10
0.88±0.07
阴道分泌物
, 百拇医药
48
39(81.3)
8.50±0.13
0.90±0.03
口腔分泌物
29
24(82.8)
8.56±0.16
0.91±0.06
皮屑
64
53(82.8)
, http://www.100md.com
8.64±0.17
0.92±0.05
鼻咽分泌物
64
52(81.3)
8.53±0.20
0.93±0.04
2.2 3株白念以106个菌细胞/只注射小白鼠,Ⅰ株有5只小白鼠在10天内死亡(占50%),其余5只都在25天内死亡,10只小白鼠的平均生存时间为12.2天;Ⅱ株有4只小白鼠在10天内死亡(占40%),其余5只直到30天才死亡,有一只仍存活,9只小白鼠的平均生存时间为14.3天;Ⅲ株注射后25天时,10只小 白鼠仍存活,至30天时才有一只死亡(占10%),平均生存时间为大于30天(图1)。菌株蛋白酶活力(Pa)与小白鼠生存时间存在相关性(r=0.7447,P<0.01 )。表明Ⅰ株毒力强于Ⅱ株,Ⅲ株毒力最弱。
, http://www.100md.com
图1 三株白念(Ⅰ、Ⅱ、Ⅲ)以106个菌细胞注射小白鼠后的死亡率
2.3 3株白念以103个菌细胞/只注射小白鼠后的体内生长率 Ⅰ株白 念在肾脏快速生长,在第10天菌落数达高峰,高达106,至15~20天仍维持在1 05;Ⅱ株白念也是快速生长,但到第10天菌落数达高峰才达105,第20天降到 103;Ⅲ株似乎没有生长且到20天时肾脏未能检出(图2)。经对菌株在体内的生长 率作对数转化后,Pa与其存在负相关(r=-0.5880,P<0.05)。结果显示 Ⅰ株在小白鼠体内生长率最快,维持时间最长;Ⅱ株其次;Ⅲ株基本不生长。
图2 三株白念(Ⅰ、Ⅱ、Ⅲ) 103个菌细胞注射小白鼠后肾脏菌落数
, http://www.100md.com
3 讨论
测定白念蛋白酶活力的方法已有两种,一是由Odds and Abbott报道的借助于BSA琼脂(pH3.8)为基础的检测法[6];二是由Kwon-Chung等建立的以BH琼脂(pH5.5 )为基础的方法[2]。两法是以牛血清白蛋白或牛血红蛋白为基质,观察蛋白酶分解产生的透明圈加以检测的,但孵育时间需要一周,难以适应临床快诊需要。本研究是自制的生物形态分型培养基经接种30℃孵育2天后,白念形成特征性红褐色色素环为依据进行检测的。实验中,在培养基上加入羧基蛋白酶抑制剂抑胃肽(Sigma,2.5μg/ml)时,该色素环完全消失,提示该色素环是白念分泌蛋白酶到培养基,并分解培养基中的血红蛋白所致。抑胃肽对蛋白酶的完全抑制作用与Ray and Payne报道[1]相同。实验还发现类星形念珠菌,个别热带念珠菌和近平滑念珠菌也产生类似色素环,但颜色较淡;而高里氏等其它念珠菌不产生色素环如图所示。该三种念珠菌均可能分泌蛋白酶,但其组成有别于白念的蛋白酶[7]。因此,该法也适用于其它念珠菌的蛋白酶活力的测定,而且该色素环已用于白念的快速分离鉴定[8],还用于白念生物形态分型法[5]的分型依据之一。该法简便,结果易判定,培养基可商品化,且稳定性好,易于推广应用。
, http://www.100md.com
照片 4种标准念珠菌(A、B、C、D)的蛋白酶活力结果(黑白1a,彩色1b)
A,D:白念珠菌JC1A,JC1B;B:高里氏念珠菌JC6;C:类星形 念珠菌JC2
本研究中,自血液和脑脊液的分离株大多数具有致病性,因为蛋白酶阳性率分别达96.9%和100%,Pa值也较低。尿液和痰的菌株大多数也认为有致病性,因蛋白酶阳性率也分别达100%和91.2%,Pa值也不高。为了进一步探讨蛋白酶活力与毒力的关系,本研究选择3株蛋白酶活力不同的菌株进行小白鼠毒力试验。一方面,以106个菌细胞/只注射小白鼠确定死亡率;另一方面,以103个菌细胞/只注射小白鼠以检测白念体内生长率。结果体外产生强蛋白酶活力的Ⅰ株在小白鼠注射25天内就引起致命感染(占100%);弱蛋白酶活力的Ⅱ株在25天内才引起8只小白鼠致命(占80%),到30天才9只死亡(占90%);无蛋白酶活力的Ⅲ株在25天内小白鼠全部存活,到30天才有1只死亡(占10%)。而且Ⅰ株小白鼠平均生存时间短于Ⅱ株,Ⅲ株最长。另外,Ⅰ株在肾脏的生长率快于Ⅱ株,表现在峰值高,上升速度快和下降速度慢。Ⅲ株基本上没有在肾脏生长。小白鼠的死亡率与体内菌株生长率结果基本吻合,提示Ⅰ株毒力强于Ⅱ株,Ⅲ株毒力最弱,说明蛋白酶活力越强,毒力就越强,致病性也越强,即白念毒力强弱与其蛋白酶活力水平密切相关(P<0.05)。Kwon-Chung报道[2]蛋白酶活力是白念的毒力因子之一。Ray and Payne还报道[1]酸性蛋白酶可能参与白念对表皮 角质细胞的粘附与侵袭过程。席丽艳摘报[9]研究证实表皮松解蛋白酶活性与毒力有直接关系。蛋白酶参与白念致病过程的机制值得进一步探讨。
, http://www.100md.com
本研究建立的方法能准确地快速简便检测临床分离白念菌株的蛋白酶活力,且可提供一 种体外直接指示毒力的方法,为进一步研究白念致病性及流行病学调查奠定基础。
*该项目得到福建省教委三项费资助
4 参考文献
1.Ray TL and Payne CD.Scanning Electron Microscopy of Epidermal Adherence and cavitation in Murine Candidiasis:a Role for Candida Acid Protein ase.Infect Immun,1988,56(8):1942.
2.Kwon-Chung KJ,Lehmann D,Good C,et al.Genetic evidence for role of extracellul ar proteinase in virulence of Candida albicans.Infect Immun,1985,49: 571.
, http://www.100md.com
3.Borg M and Ruchel R.Expression of extracellular acid proteinase by proteolytic Candida spp.during experimental infection of the oral mucosa.Infect Immun,1988,56:626.
4.侯幼红.白色念珠菌粘附的研究进展.国外医学微生物学分册,1994,1:23.
5.温旺荣,王德春,戴庚孙,等.白念珠菌的生物形态分型研究.中国人兽共患病杂志,1995, 11(2):11.
6.Odds FC,and Abbott AB.A simple system for the presumptive identification of Candida albicans and differentiation of strains within the species.Sab ouraudia,1980,18:301.
, 百拇医药
7.Ruchel R,Boning B, and Borg M.Characterization of a secretory proteinase of Candida parapsilosis and eidence for the absence of the enzyme during infection in vitro.Infect Immun,1986,53:411.
8.温旺荣,王德春,陈红,等.平板色素环法快速分离鉴定白色念珠菌.福建医科大学学报, 1997,31(1):25.
9.席丽艳摘.白念珠菌表皮松解蛋白酶活力与其对小鼠毒力的关系.国外医学皮肤性病学分册 ,1995,21(2):124.
1998年11月5日收稿, 百拇医药